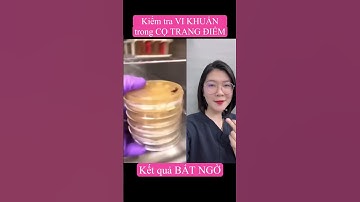
Review - Kiểm tra VI KHUẨN trong CỌ, MÚT TRANG ĐIỂM #thsbsphuongquy #review #reaction #shorts

⬇ DOWNLOAD NOW
Kalau muncul iklan pop-up, tutup lalu klik tombol kembali
Download lagu Cọ cứng xơ vì không làm sạch đúng cách? Đừng lo! | Soap Rửa Cọ Trang Điểm Glorie secara gratis hanya untuk keperluan promosi. Dukung artis favorit kamu dengan membeli musik original di iTunes atau platform resmi lainnya.
Review - Kiểm tra VI KHUẨN trong CỌ, MÚT TRANG ĐIỂM #thsbsphuongquy #review #reaction #shorts
Review - Kiểm tra VI KHUẨN trong CỌ, MÚT TRANG ĐIỂM #thsbsphuongquy #review #reaction #shorts
 Cách xử lý cọ sơn bị khô
Cách xử lý cọ sơn bị khô
 CÁCH GIẶT CỌ VÀ MÚT TRANG ĐIỂM ĐÚNG CÁCH ♡ Ny Nguyễn
CÁCH GIẶT CỌ VÀ MÚT TRANG ĐIỂM ĐÚNG CÁCH ♡ Ny Nguyễn
 cách làm sạch cọ đúng #lamdep #meolamdep #beautyhacks
cách làm sạch cọ đúng #lamdep #meolamdep #beautyhacks
 Review set vệ sinh cọ và mút trang điểm | Châu Muối
Review set vệ sinh cọ và mút trang điểm | Châu Muối
 SWATCH & REVIEW 💞 NƯỚC RỬA CỌ DAISO 💞 Mint Cosmetics
SWATCH & REVIEW 💞 NƯỚC RỬA CỌ DAISO 💞 Mint Cosmetics
 Hướng dẫn vệ sinh cọ trang điểm sạch & đơn giản - How I clean my make up brushes #4 | Emily Phương
Hướng dẫn vệ sinh cọ trang điểm sạch & đơn giản - How I clean my make up brushes #4 | Emily Phương
 Cách giặt rửa cọ trang điểm đúng cách đơn giản tại nhà | Đỗ Thuý Ngà Official |
Cách giặt rửa cọ trang điểm đúng cách đơn giản tại nhà | Đỗ Thuý Ngà Official |